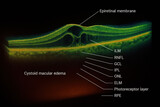
OCT Scan Showing Cystoid Macular Edema and Epiretinal Membrane - Illustration

Plakaty Siatkówka
Plakaty Siatkówka
Wystarczy zebrać się w kilka osób i już możemy zagrać chociażby w siatkówkę. Przy tej profesjonalnej wymagane jest jeszcze odpowiednio wymierzone boisko. Nie mniej jednak w przypadku kiedy gramy z przyjaciółmi to bardziej liczy się dobra zabawa, aniżeli sztywne reguły gry. Nie mniej jednak jeżeli chcielibyśmy kadr z meczu siatkówki wykorzystać do dekoracji pomieszczenia to o wiele lepiej sprawdzi się fototapeta siatkówka, n której będziemy mieli profesjonalny mecz. Dzięki temu będzie to wyglądało tak jakby np. kadra narodowa grała u nas w domu. Poza tym w takiej sytuacji to nie tylko taka sytuacji musi znajdować się na fototapecie siatkówka. Równie ciekawie będzie wyglądał widok na samo boisko lub też po prostu wzór ułożony z piłek do siatkówki. Jeżeli chcemy wprowadzić do pomieszczenia nieco wakacyjnych wspomnień, a jednocześnie nie bardzo mamy ochotę rezygnować ze sportowych dekoracji to możemy połączyć te dwa elementy na jednej dekoracji ściennej. Najlepiej do tego będzie się nadawała fototapeta, na której mamy siatkówkę plażową.Nie znalazłeś tego czego szukałeś?
Opisz Dokładnie jakiego zdjęcia lub wzoru szukasz. Podaj także żądany rozmiar.Postaramy się odnaleźć dla Ciebie to co Cię interesuje lub prześlemy podobne propozycje.

Czech
French
German